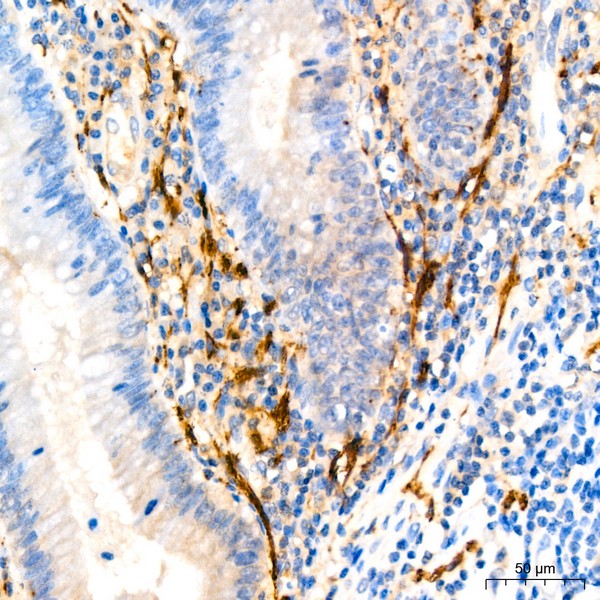
A22010: Calretinin Rabbit mAb

Calretinin Rabbit mAb (A22010)
$148.00 – $548.00
Abclonal Calretinin Rabbit mAb (Catalog Number: A22010) encodes an intracellular calcium-binding protein belonging to the troponin C superfamily. Members of this protein family have six EF-hand domains which bind calcium.
- Details & Specifications
- References
| Catalog No. | A22010 |
|---|---|
| Product Name | Calretinin Rabbit mAb (A22010) |
| Supplier Name | ABclonal, Inc. |
| Brand Name | Abclonal |
| Synonyms | CR; CAL2; CAB29 |
| Gene Name | CALB2 |
| Protein Name | CALB2 |
| Uniprot/Swissprot ID | P22676 |
| Gene ID | 794 |
| Clone | ARC53573 |
| Clonality | Monoclonal |
| Source/Host | Rabbit |
| Reactivity | Human, Mouse, Rat |
| Conjugate | Unconjugated |
| Note | Products will be shipped from the warehouse in Massachusetts. Promotion is running from time to time. Welcome to send a request for quote to message@sydlabs.com. |
| Order Offline | Syd Labs, Inc. 4 Avenue E, Hopkinton, MA 01748 USA. Phone: 1-617-401-8149 Fax: 1-617-606-5019 Email: message@sydlabs.com |
Description
A22010: Calretinin Rabbit mAb
This gene encodes an intracellular calcium-binding protein belonging to the troponin C superfamily. Members of this protein family have six EF-hand domains which bind calcium. This protein plays a role in diverse cellular functions, including message targeting and intracellular calcium buffering. It also functions as a modulator of neuronal excitability, and is a diagnostic marker for some human diseases, including Hirschsprung disease and some cancers. Alternative splicing results in multiple transcript variants.
Immunogen Information about Calretinin Rabbit mAb (A22010)
Immunogen:Recombinant fusion protein containing a sequence corresponding to amino acids 1-271 of human Calretinin (NP_001731.2).
Sequence:MAGPQQQPPYLHLAELTASQFLEIWKHFDADGNGYIEGKELENFFQELEKARKGSGMMSKSDNFGEKMKEFMQKYDKNSDGKIEMAELAQILPTEENFLLCFRQHVGSSAEFMEAWRKYDTDRSGYIEANELKGFLSDLLKKANRPYDEPKLQEYTQTILRMFDLNGDGKLGLSEMSRLLPVQENFLLKFQGMKLTSEEFNAIFTFYDKDRSGYIDEHELDALLKDLYEKNKKEMNIQQLTNYRKSVMSLAEAGKLYRKDLEIVLCSEPPM
Gene ID:794
Swiss prot:P22676
Synonyms:CR; CAL2; CAB29; Calretinin
Calculated MW:32kDa
Observed MW:29kDa
Images of Calretinin Rabbit mAb (A22010)

Western blot analysis of various lysates using Calretinin Rabbit mAb (A22010) at1:110000 dilution.
Secondary antibody: HRP Goat Anti-Rabbit IgG (H+L) (AS014) at 1:10000 dilution.
Lysates/proteins: 25μg per lane.
Blocking buffer: 3% nonfat dry milk in TBST.
Detection: ECL Basic Kit (RM00020).
Exposure time: 10s.

Immunohistochemistry analysis of Calretinin in paraffin-embedded human appendix using Calretinin Rabbit mAb (A22010) at dilution of 1:200 (40x lens).Perform high pressure antigen retrieval with 10 mM Tris/EDTA buffer pH 9.0 before commencing with IHC staining protocol.

Immunohistochemistry analysis of Calretinin in paraffin-embedded Human mesothelioma using Calretinin Rabbit mAb (A22010) at dilution of 1:200 (40x lens).Perform high pressure antigen retrieval with 10 mM Tris/EDTA buffer pH 9.0 before commencing with IHC staining protocol.

Confocal imaging of paraffin-embedded Mouse brain tissue using Calretinin Rabbit mAb (A22010, dilution 1:200) followed by a further incubation with Cy3 Goat Anti-Rabbit IgG (H+L) (AS007, dilution 1:500) (Red). DAPI was used for nuclear staining (Blue). Objective: 40x. Perform microwave antigen retrieval with 0.01 M citrate buffer (pH 6.0) prior to IF staining.
Please remember our product information: Calretinin Rabbit mAb (Catalog Number: A22010) Abclonal